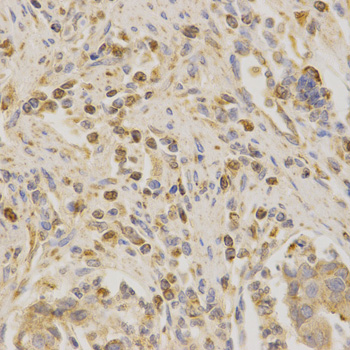

For quotations, please use our online quotation form, and you may also contact us by
service@kendallscientific.com
+1-888.733.6849 (Toll-free)
+1-617.299.7367 (Int’l))
+1-888.733.6849
Our customer service representatives are available 24 hours, Monday through Friday to assist you.| Reactivity | Human Mouse Rat |
| Tested applications | WB IHC ICC IF |
| Recommended Dilution | WB 1:500 - 1:2000 IHC 1:50 - 1:200 ICC 1:50 - 1:200 IF 1:50 - 1:200 |
| Calculated MW | 23kDa |
| Observed MW | Refer to Figures |
| Immunogen | A synthetic peptide of human BAK1 |
| Storage Buffer | Store at -20℃. Avoid freeze / thaw cycles. Buffer: PBS with 0.02% sodium azide, 50% glycerol, pH7.3. |
| Concentration | bh |
| Synonym | BAK1;BAK;BAK-LIKE;BCL2L7;CDN1;MGC117255;MGC3887 ; |

Western blot analysis of extracts of MCF7 cell lines, using BAK1 antibody.

Immunohistochemistry of paraffin-embedded human kidney cancer using Bak1 antibody at dilution of 1:200 (x400 lens).
Immunohistochemistry of paraffin-embedded human stomach cancer using Bak1 antibody at dilution of 1:200 (x400 lens).

Immunohistochemistry of paraffin-embedded rat heart using BAK1 antibody at dilution of 1:100 (x400 lens).

Immunofluorescence analysis of HeLa cell using Bak1 antibody. Blue: DAPI for nuclear staining.
Bak is a proapoptotic member of the Bcl-2 family (1). This protein is located on the outer membrane of mitochondria and is an essential component for transduction of apoptotic signals through the mitochondrial pathway (2,3). Upon apoptotic stimulation, an upstream stimulator like truncated BID (tBID) induces conformational changes in Bak to form oligomer channels in the mitochondrial membrane for cytochrome c release. The release of cytochrome c to the cytosol activates the caspase-9 pathway and eventually leads to cell death (4,5).
N/A